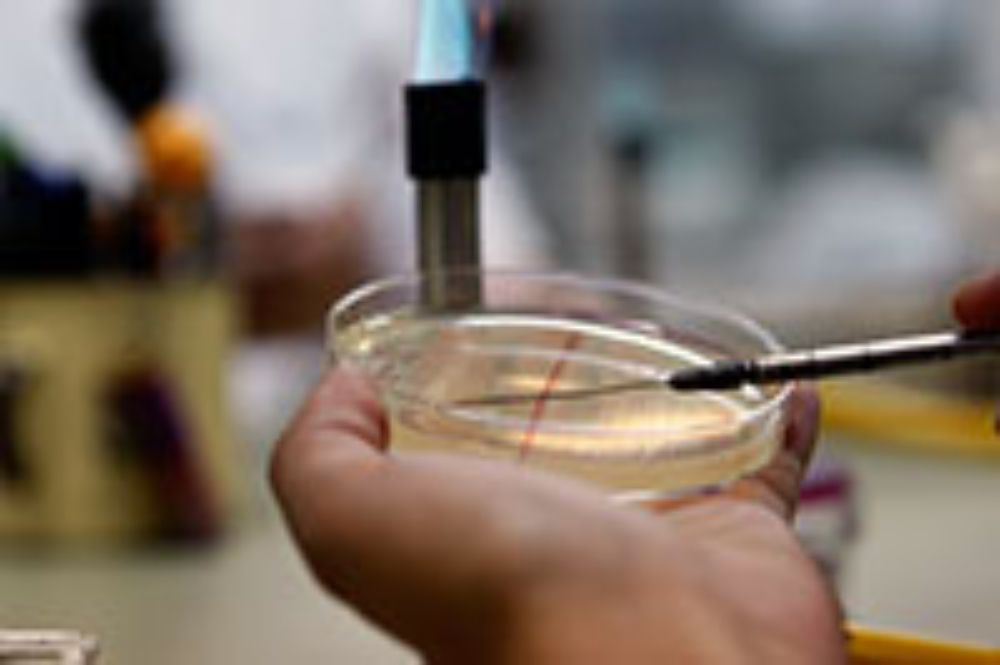
Ciencias, internacionalización, doctorado, investigación

Fortalecimiento y consolidación internacional de la investigación y los Programas de Doctorado en Ciencias mención Microbiología y Doctorado en Biotecnología Molecular de la Universidad de Chile
El proyecto está dirigido a fortalecer la internacionalización, con foco en Latinoamérica, de los programas de Doctorado en Ciencias mención Microbiología y Doctorado en Biotecnología Molecular de la Universidad de Chile. La iniciativa está sustentada en la experiencia internacional adquirida por ambos programas a través de proyectos y publicaciones conjuntas de carácter internacional que han permitido la construcción de redes de contacto con Latinoamérica y el resto del mundo.
A partir de esta experiencia, el proyecto busca constituirse en un núcleo formativo para los estudiantes de la región y fomentar una transferencia de conocimientos desde el área microbiológica hacia la formación de alumnos con experiencia biotecnológica para aplicarlos de manera efectiva a problemas país. Con el fin de dar cumplimiento a estos fines, la prouestatiene como ejes estratégicos la expansión de la movilidad académica y estudiantil, hacia y desde el extranjero; el aumento de las publicaciones conjuntas con unidades académicas internacionales; y el fortalecimiento de la difusión de los programas de investigación y formación doctoral involucrados.
Objetivos específicos de la iniciativa:
- Potenciar la proyección internacional de los estudiantes de ambos programas de Doctorado.
- Fortalecer la colaboración académica internacional con instituciones extranjeras de excelencia, con especial énfasis en Latinoamérica, y servir de nexo entre centros científicos consolidados de países desarrollados y países latinoamericanos en vías de desarrollo.
- Difundir la potencialidad de internacionalización de ambos programas de doctorado en el extranjero, particularmente en Latinoamérica.
Unidad coordinadora
- Escuela de Postgrado de la Facultad de Ciencias y comités académicos de los programas de Dotorado en Ciencias mención Microbiología y Doctorado en Bioteconología Molecular
Unidades Participantes
- Escuela de Postgrado, Facultad de Ciencias
- Doctorado en Ciencias mención Microbiología
- Doctorado en Bioteconología Molecular
- Departamento de Biología, Facultad de Ciencias
- Departamento de Ciencias Ecológicas, Facultad de Ciencias
- Facultad de Medicina
- Facultad de Ciencias Químicas y Farmacéuticas
- Facultad de Ciencias Físicas y Matemáticas
- Instituto de Nutrición y Teconología de los Alimentos (INTA)
Director Académico del Proyecto: Octavio Monasterio Opazo